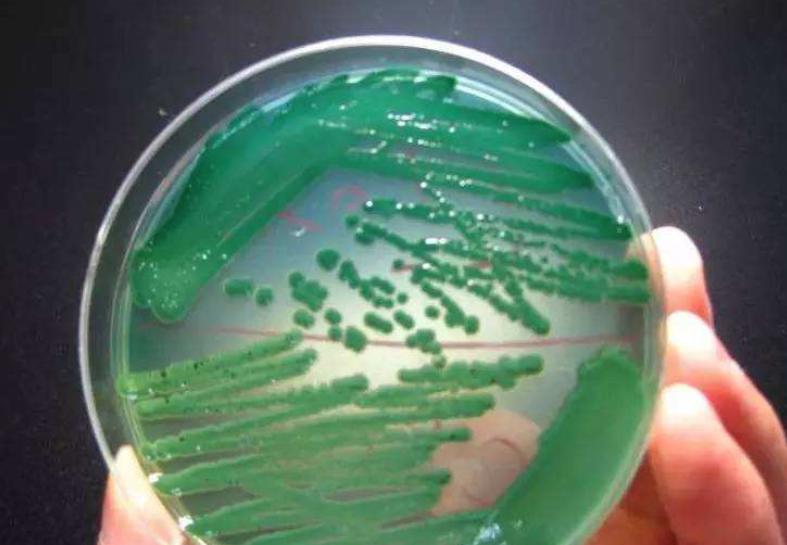
南美虾空肠空胃怎么解决,虾空肠空胃死亡原因

早在四、五年前,华南对虾土塘养殖的过程中就有白便出现,当时发病率低、危害小,通过常规的水质调节和内服清热解毒和保肝类中药或直接使用抗生素就能治愈,没能引起人们的关注。
多数虾塘发生白便之后不久就开始出现空肠、空胃游塘,继续恶化后出现趴边“偷死”。
对于许多经历过“浩劫”的虾农而言,谈白便色变!

虾农总结养虾有三关:“白便”“空肠空胃”和“偷死”(死虾肝脏萎缩、壳肉分离)。
目前“偷死”已成危害养虾业的头号杀手,可以说白便是偷死的初始阶段,为“偷死”亮起了红灯,所以我们预防白便治疗白便最能有效遏制后期的“空肠空胃”,以及“偷死”造成的巨大损失。
一系列可能引发“白便”的因素:
1.虾苗幼体肝胰脏的健康程度,肝胰脏的结构和功能是否健全
2.苗场标苗期间是否用过伤害肝胰脏的产品,比如过量的抗生素
3.养殖期间水质底质、天气是否恶化,尤其是弧菌是否超标
4.养殖期间对虾是否吃到乃至长期吃到伤肝的食物。如:副溶血性弧菌、腐败霉变的饲料、死藻或其它含化工成分的伤肝食物。
“白便”的症状
虾粪细长呈白色(如棉线)、有粘性、浮在水面、大量聚集有恶臭散发。
初始阶段对虾摄食正常,但随着病情加重,出现吃料慢甚至不吃料或虾身瘦弱(壳肉分离),且伴随游塘及偷死(虾肠道发红或肠道有白色脓状物)。
典型的肠道病理变化为粘膜下层细胞增生, 上皮细胞脱落;增生并纤维化的细胞层整体脱落,且可多次脱落,形成多次白便。
“白便”的原因分析
细菌感染
实验室发现,“白便”的主要成分为肝胰脏排出的病变组织、粘液和毒液,肠道脱落的粘膜以及一些正常的粪便成分,而非人们常规认为的虾粪便。

我们从中检测出大量的副溶血弧菌、哈维氏弧菌、创伤弧菌等致病菌。这些致病菌聚集在池塘底部,附着在饲料、残饵、有机碎屑、死藻上不断繁殖生长。
对虾吃食这些物质后,通常引起胃肠道感染、心肌损害、肝胰脏明显萎缩。很多发病池塘停料后,对虾发病程度明显减轻。细菌感染建议拌料内服液肽美+止血肠鳃康+白便速止,有效预防细菌感染一起的白便,空肠空胃,肠炎等。

点击查看—— 赛有渔-液肽美
点击查看—— 赛有渔-止血肠鳃康
点击查看—— 赛有渔-白便速止
藻毒素
藻毒素可分为两类:
一类为具有生物活性的七肽单环肝毒素,主要为微囊藻毒素
另一类为神经毒素,主要为鱼腥藻毒素-a。
肝毒素直接导致肝胰脏肿大、萎缩、出血、坏死以及胃肠道炎症、坏死等病变。
神经毒素是一种潜在的神经肌肉传导阻止剂,它可以在短时间内导致骨骼肌肉等瘫痪,重症者可因呼吸系统屏障而致死。
水质恶化
南美白对虾是底栖动物,在他们生活的中下层水体,由于残饵、粪便、死藻的大量累积以及滥用絮凝性底改等因素导致该层水质、底质发热、发臭、泛酸,生物和化学耗氧量大,氨氮、亚硝酸盐等有毒物质严重超标,成为原生动物、细菌、病毒的滋生地,成为名副其实的“聚毒层”。

“聚毒层”如不及时消除,就会加重肝胰脏负担,腐蚀肠粘膜,最终导致“白便”。
往往并发黑鳃、黄鳃、烂鳃、烂眼、红须、红尾、烂尾、断须、白浊等症状。

霉菌毒素
由于劣质的原料和贮存方法不当等原因,往往造成饲料中霉菌毒素超标。
长期食用霉变的饲料,造成肝细胞坏死,肝胰脏解毒和消化功能障碍。
导致肠内黏膜和血细胞的坏死,这些细胞可以产生胰腺,胃腺,使一些器官颜色变浅。
这些副作用反过来又导致对虾生长缓慢,饲料效果变差。
霉菌毒素使对虾机体免疫受到抑制,容易诱发大规模的疾病。
滥用药物
滥用抗生素、消毒剂、杀虫剂均能导致对虾肝胰脏出现不同程度的损伤,导致肝功能障碍。

关于“白便”的讨论
我们认为, “白便”的实质是细菌、藻毒、水质、霉菌、药物等综合作用肝胰脏所致。
肝胰脏作为对虾体内最大最重要的内脏器官,它的被侵害与损伤,是导致“白便”“空肠空胃”“偷死综合症”的直接原因。
大多数人认为“白便”是肠道的产物,发生“白便”时候肠道会出现一系列的症状,基于这些表象,人们就定义为“白便”为肠炎,是否就是“肠炎”一说呢?
众所周知,肝胰脏具有解毒、消化、免疫调节等功能,是对虾体内最大最重要的内脏器官,对虾大多数疾病都和肝胰脏有关。

肝胰脏的组织和细胞遭受以上原因的侵害发生病变,就会引起解毒功能下降,引发消化液分泌失常,直接导致消化液中消化酶特别是蛋白酶成分结构和功能异常,而异常的蛋白酶会导致肠道内蛋白质消化分解异常,于是蛋白质不会彻底地被分解为最终产物氨基酸,就被分解为中间产物——眎或者是胨。
这种成分存留在肠道中短时间内得不到进一步分解,受理化因素影响,就很快变性或变质,形成粘性聚合物,产生发臭的异味。
这种聚合物含刺激肠粘膜的有毒成分,会引起肠粘膜脱落、增生、肠道发红等,这种聚合物难溶于水,密度比水小,或者说比重轻。

如果排出体外的虾便中占的比例过大,就会悬浮水中或漂浮于水面,这种聚合物在肠道内一般呈浅棕色,排出体外经水解氧化发生颜色反应后呈现乳白色,我们称之为“白便”。
“白便”的主要成分为肝脏排出的病变组织、粘液和毒液,肠道脱落的粘膜以及一些正常的粪便成分,并非对虾粪便,也不是肠粘膜等肠道组织。
而所表现的“肠炎”症状也是基于肝胰脏病变后的表现。由此可见“白便”不属肠炎而属于肝炎。
养虾有三关:“白便”“空肠空胃”和“偷死”。
目前“偷死”已成危害养虾业的头号杀手,“白便”是“偷死”的初始阶段,为“偷死”亮起了红灯,所以我们预防“白便”治疗“白便”能有效的杜绝“空肠空胃”和“偷死”为对虾养殖带来的巨大损失。

“白便”是细菌、藻毒、水质、霉菌、药物等综合作用的结果,对待“白便”应立足于“无病先防、有病早治、以防为主、防治结合”的原则。
只有从提高对虾体质、改善和优化水体环境、切断病原体传播途径等方面着手,开展综合和推广健康养殖模式,才能达到杜绝“白便”治疗“白便”的目的。

把握好“白便”这一关,是关系到对虾养殖是否成功的关键一关。
至于“白便”是肠炎还是肝炎一说,我们也不必过多的讨论,只要我们定期做到“整肠保肝”“调节水质”,合理的放养比例与密度,做到养殖过程中全方位的管理,“白便”也就无可乘之机了,我们就已成功了一半。
平时在拌料过程中可以添加金肝利胆+白便速止+止血肠鳃康+液肽美,金肝利胆能够促进脂肪的消化吸收和帮助肝胰腺进行解毒和排毒,减轻肝胰腺的负担,保护肝胰腺健康,提高自身免疫力;止血肠鳃康具有抗菌抗病毒、保护肠道的效果,搭配超能丁酸菌种使用保护肝脏和肠道,降低白便的发病率。
文章来源于网络,如有侵权请联系删除。
点击查看——赛有渔-金肝利胆
点击查看——赛有渔-丁酸菌种
点击查看——赛有渔-乳酸菌种